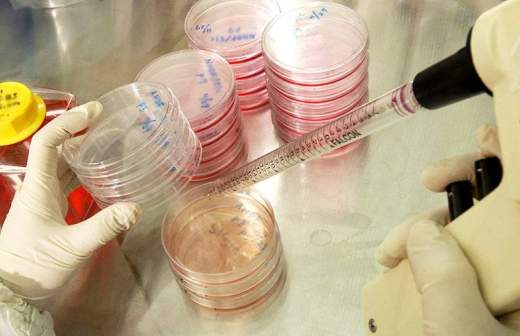

Клетки доросли до пациентов

Выращенные в лабораториях ткани и органы будут доступны россиянам в следующем году. Больше 30 таких клеточных продуктов уже в высокой степени готовности, сообщил «Известиям» директор департамента Минздрава РФ Игорь Коробко. В том числе — выращенные лабораторным путем кожа, хрящевые ткани и продукты для замещения инсулинпродуцирующих клеток при диабете 1-го типа. Процедуру их получения Минздрав должен определить до конца года.
Российские биомедицинские разработки вскоре выйдут за пределы научных лабораторий.
— Подача документов на регистрацию таких продуктов должна начаться уже с 1 января 2018 года, – пояснил директор департамента науки, инновационного развития и управления медико-биологическими рисками здоровью Минздрава Игорь Коробко. — Закон готов. Он очень сложный, потому что это абсолютно новая область регулирования. Это не лекарства, не медицинские изделия, а отдельный тип продуктов, который будет использоваться.
Закон «О биомедицинских клеточных продуктах» (180-ФЗ) был подписан в июне прошлого года. Часть его положений вступила в силу с 1 января 2017-го, часть — вступит с 1 января 2018-го (например, о правилах производства клеточных продуктов). Сейчас идет принятие подзаконных актов, регулирующих эту сферу. В этом процессе и будет определено, каким образом ткани и органы из лабораторий могут быть доступны россиянам. Пока решения по этому вопросу нет. Теоретически существует два основных варианта: через систему высокотехнологичной медицинской помощи или обязательного медицинского страхования.
Как рассказала «Известиям» министр здравоохранения Вероника Скворцова, с принятием 180-ФЗ в России произошел рывок в развитии клеточных технологий, позволяющий стране выйти в лидеры в этой области.
— Российская медицина обладает мощной научной базой, позволяющей ей быть конкурентоспособной на международном уровне. Например, созданная в рекордно короткие сроки вакцина от Эболы (на основе биомедицинских технологий. — «Известия») и сегодня превосходит мировой уровень, продолжая оставаться единственной в мире зарегистрированной вакциной, — сообщила Вероника Скворцова.
Но чтобы закон о биомедицине заработал в полной мере, должны быть внесены изменения в ряд других федеральных нормативных документов, которые определяют, что производство клеточных продуктов — лицензируемый вид деятельности. Сейчас Минздрав прорабатывает этот вопрос. По словам Игоря Коробко, то, какие именно клеточные продукты первыми дойдут до населения, зависит от готовности производителей пойти на инвестиции.
— Закон потребует от производителей технического дооснащения, принятия и выполнения правил надлежащей практики, которая обеспечивает качество этих продуктов. В высокой степени готовности находятся больше 30 клеточных продуктов, — пояснил Коробко.
Среди уже практически готовых — выращенные лабораторным путем кожа, хрящевые ткани и продукты для замещения инсулинпродуцирующих клеток при диабете 1-го типа.
— Также можно говорить о создании биологических лекарственных препаратов. Отечественный производитель уже прошел стадию производства дженериков. Она позволила появиться современной российской высокотехнологичной биофармацевтической промышленности. Сейчас идет переход к разработке и производству оригинальных препаратов. Это уже свои молекулы, которые имеют патентную защиту. Российские производители сейчас активно начинают выходить с этими препаратами на международные рынки, — пояснил Игорь Коробко.
По словам Вероники Скворцовой, важность развития биомедицинских технологий очевидна.
— Это лечение — именно лечение, а не коррекция симптомов, — наследственных и аутоиммунных заболеваний, регенерация органов и восстановление утраченных функций организма, — сообщила министр. — В области биомедицины создаются центры доклинических исследований, позволяющие проводить разработки биомедицинских клеточных продуктов, лекарственных препаратов, в том числе биотехнологических, на мировом уровне и с соблюдением всех мировых стандартов.
По словам министра, первая такая клиника на базе Национального медицинского исследовательского центра имени Алмазова в Санкт-Петербурге была открыта в прошлом году. Аналогичный центр сейчас строится в Москве, в Российском научно-исследовательском медицинском университете имени Пирогова. Также в этом году начато создание в Обнинске уникального центра доклинических исследований радиофармпрепаратов (используются в основном для лучевой терапии злокачественных опухолей). Новое поколение этих средств разрабатывается в том числе с применением биотехнологий и обладает улучшенными свойствами (таргетные радиофармпрепараты).